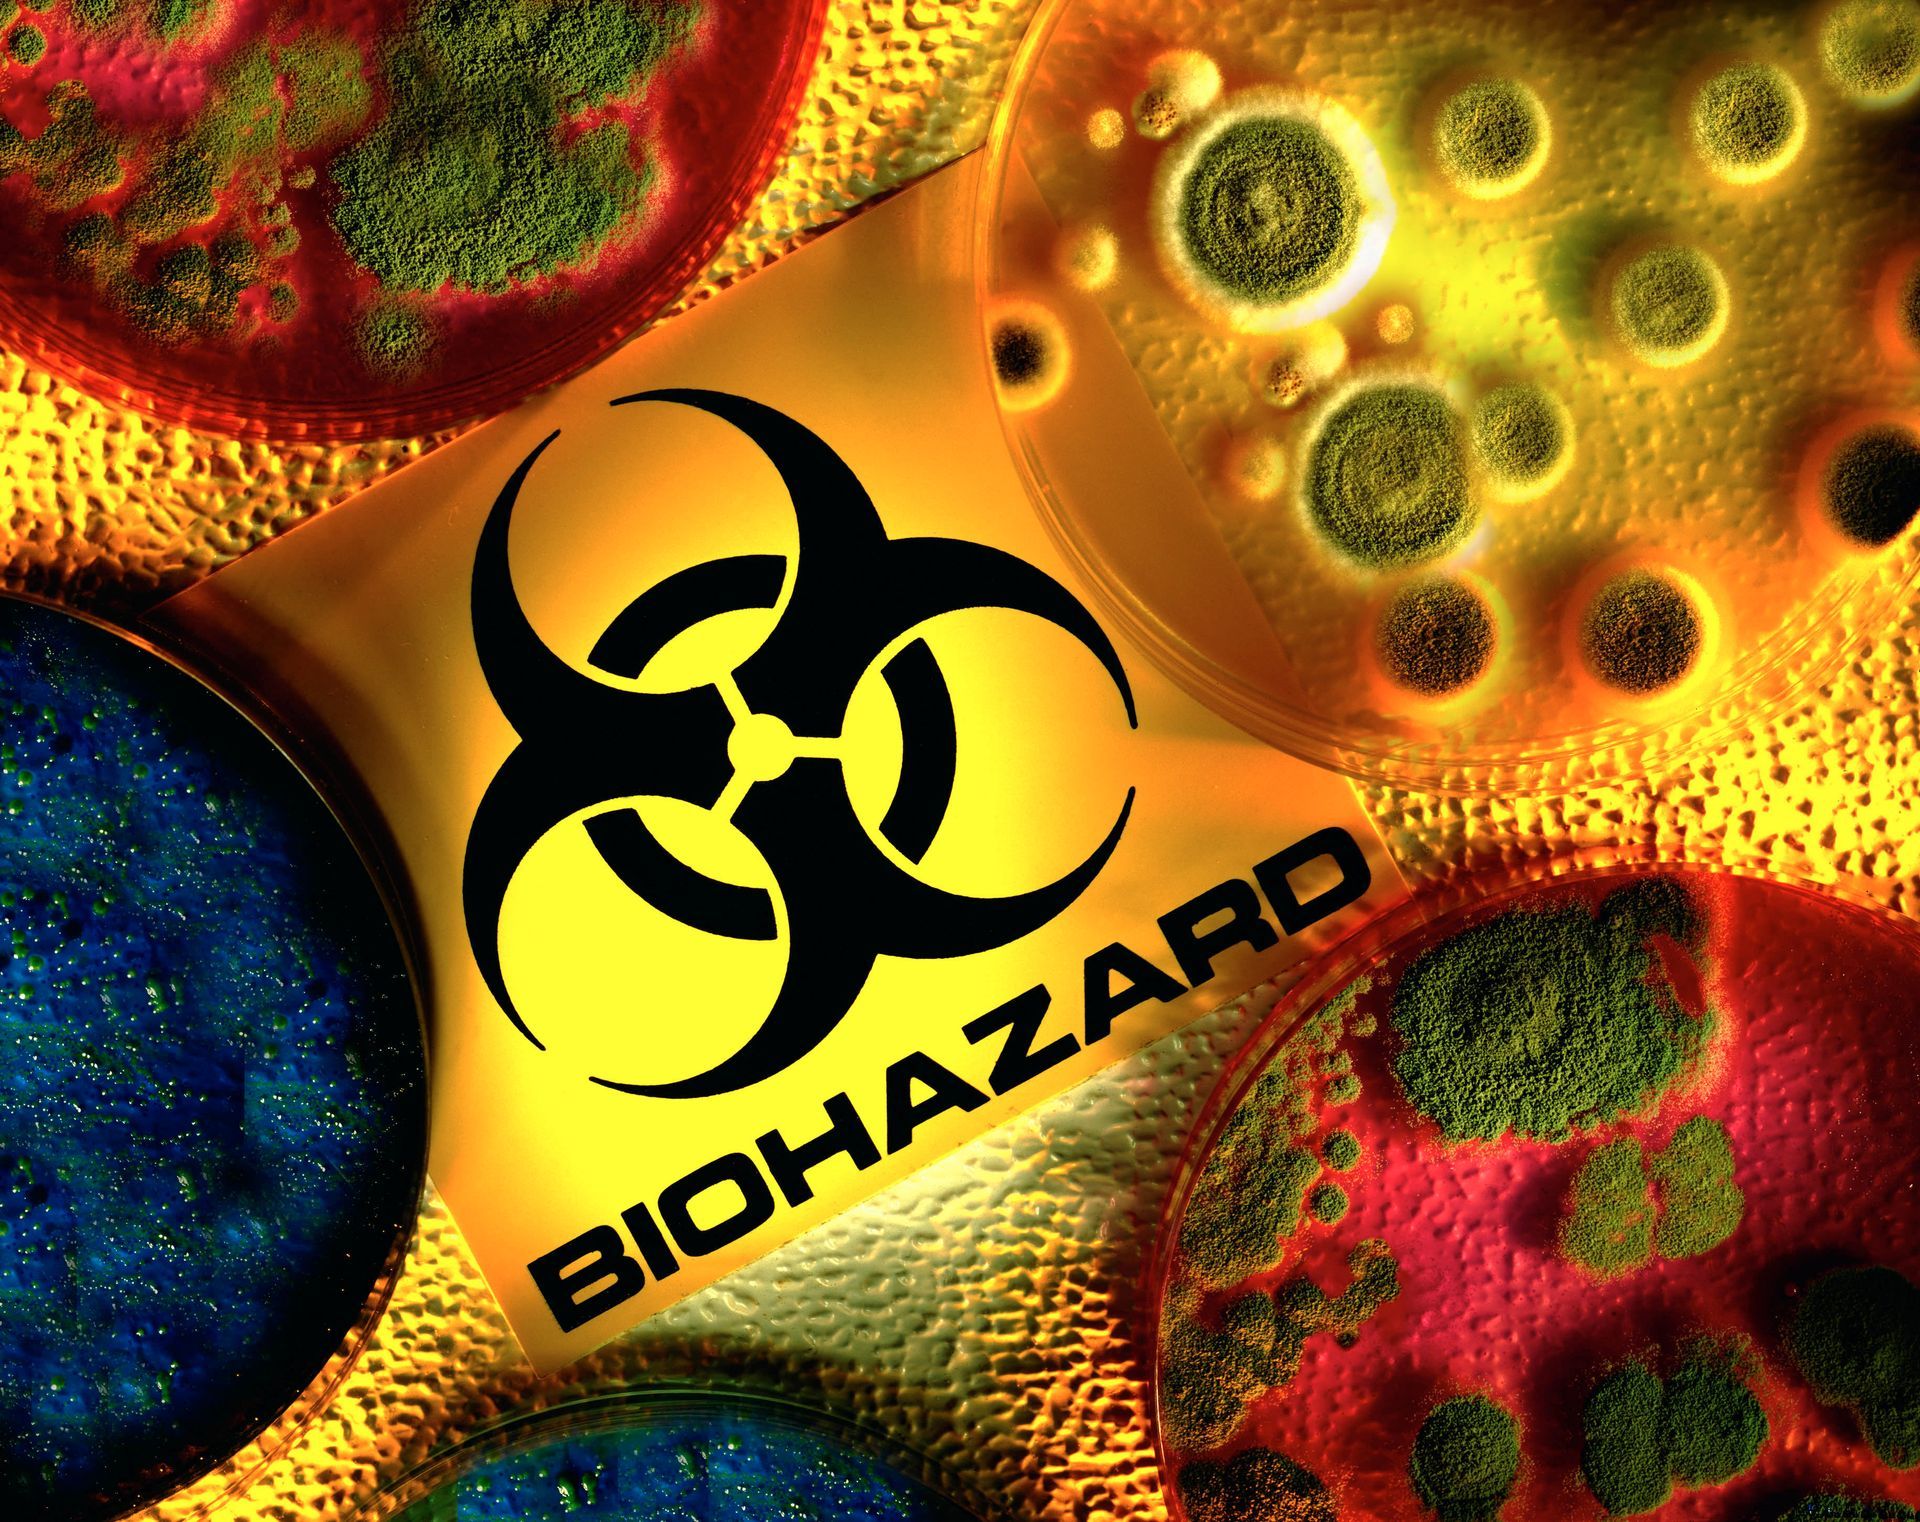

Among the Carpet Cleaning Companies La Crosse, WI Turns to for Quality Work
At America's Best Cleaning & Restoration Services, we proudly cater to both residential and commercial clients across La Crosse, WI, Rochester, MN, and the surrounding areas. Along with being a comprehensive restoration service for fire damage, water damage, and mold remediation, we also excel in general cleaning. Our cleaning services include carpet and furniture cleaning, air duct maintenance, and certified biohazard cleanup. Our skilled technicians are adept at swiftly returning your home or business to optimal conditions, making us the first choice among carpet cleaning companies in La Crosse, WI.
Our skilled technicians are adept at swiftly returning your home or business to optimal conditions. Understanding the emotional toll that calamities like fires or floods can have, our aim is to alleviate your stress and ensure your utmost comfort. To further ease your concerns, we collaborate with most insurance companies and will work with them directly on your behalf. We are at your service 24/7, every day of the week. We're proud to be one of the top damage restoration and carpet cleaning companies in La Crosse, WI, and surrounding areas. Reach out to us today for a comprehensive restoration consultation.
Why Choose America's Best Cleaning & Restoration Services?
America's Best Cleaning & Restoration Services' dedicated team of certified cleaning technicians provides impeccable restoration cleaning and remediation solutions to the La Crosse, WI, and Rochester, MN area. From fire damage to mold remediation, carpet cleaning, and biohazard cleanup, our skilled technicians are committed to restoring your space to its prime condition. Our strong collaboration with most insurance companies ensures a hassle-free experience. With us, you're not just getting a service; you're embracing peace of mind, quality, and dedication. 24/7 emergency availability underscores our commitment to you. Choose the best; choose America's Best. Call us today.
Family-Owned and Operated Since 1987
24-Hour Emergency Water, Mold, and Fire Cleanups
Certified in Restoration, Remediation, and Cleaning
Coupons and Discounts Available
24/7 Emergency Responses and Services
Satisfaction Guaranteed
Here's what our satisfied customers are saying...
At America's Best Cleaning & Restoration Services, we're proud to provide exceptional cleaning, restoration, and remediation work to our customers. We would be grateful if you could share your experience with our cleaning company with others. Your feedback helps us improve and helps others make informed decisions. Please take a moment to leave a review of America's Best Cleaning & Restoration Services and let others know how we did.

Share On: